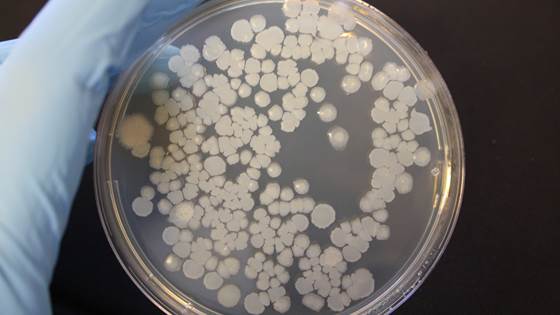
Mikrobiologisk laboratorium - SINTEF SeaLab

Vi har ekspertise innen utvikling, optimering og validering av analytiske metoder, og kan raskt tilpasse metoder til nye utfordringer. Vi tilbyr både tradisjonelle og innovative løsninger for prøveopparbeiding for enhver matriks (f.eks. vannprøver, sedimenter og biologiske prøver). Vi benytter multivariat statistikk for behandling av komplekse datasett.
Analyse av miljøgifter
- Persistente miljøgifter (PAH, PCB, PBDE, OCP)
- Farmasøytika og personlige pleieprodukter
- Plast og gummirelaterte kjemikalier
- Plast og polymerdegraderingsprodukter
- Sensitiv analyse av spormengder miljøgifter med GC-MS/MS og/eller LC-MS/MS
- Karakterisering av komplekse miljøprøver ved hjelp av to-dimensjonal gasskromatografi koblet til høytoppløselig massespektrometri (GCxGC-qToFMS)
- Identifikasjon av biotransformasjonsprodukter og metabolitter
- Analyse av polymerer og mikroplast med termisk desorpsjon og pyrolyse GC-MS
Analyse av råolje, produsert vann, petroleumsprodukter og oljesølidentifikasjon
- Analyse av total petroleum hydrokarboner, alifatiske og aromatiske hydrokarboner (> 100 analytter) utføres med GC-FID og GC-MS. Vi analyserer en utvidet liste med PAH og alkyl-substituerte PAH og fenoler
- Oljesølidentifikasjon utføres ifølge CEN Guideline CEN/TR15522-2:2012
- For analyse av komponenter i små prøver og konsentrasjoner benyttes høysensitiv GC-MS/MS
- GCxGC-FID eller GCxGC-MS benyttes til karakterisering av petroleumssammensetning
Analyse av klimagass og flyktige forbindelser
- En utvidet liste av flyktige forbindelser ('VOC'), inkludert C5-C10 alifater and C0-C5 monoaromatiske forbindelser analyseres med 'purge-and-trap' GC-MS (P&T GC-MS)
- Klimagasser analyseres med GC-FID
- Lukt- og smaksforbindelser (f.eks geosmin og metylisoborneol) analyseres med GC-MS/MS
Avansert karakterisering av biomolekyler
- Lipidkarakterisering, lipidomics og pigmentanalyser med LC-MS/MS
- Fettklasser og fettsyresammensetning med LC, LC-MS/MS og GC-FID
Skjebne- og effektstudier i kombinasjon med analytisk kjemi
I våre miljølaboratorier tilbyr vi et bredt utvalg av standardiserte og spesialiserte skjebne- og effektstudier for miljøgifter, komplekse blandinger, nano- og mikropartikler i både sjøvanns- og ferskvannsystemer. Vi tilbyr løsninger for 'whole effluent testing' (WET) og 'effect-directed analysis' (EDA).